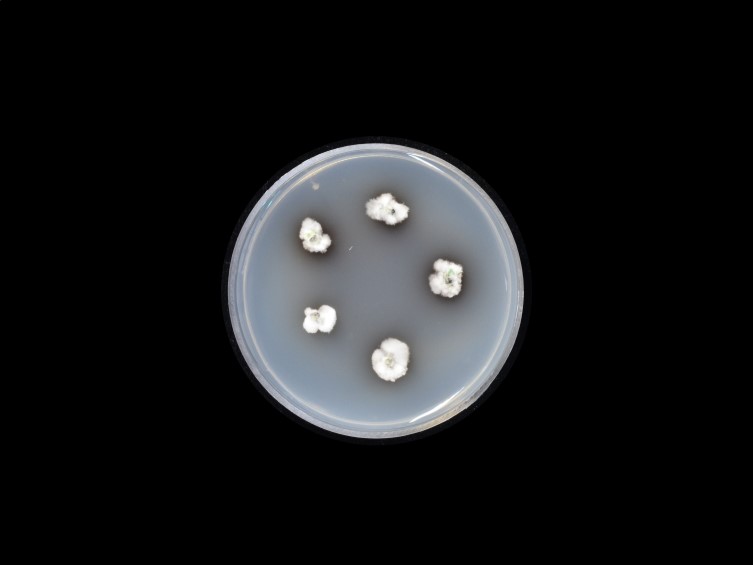

Holotype:
THAILAND, Chiang Mai Province, San Buak Wai Community Forest, 20 Aug. 2019, S. Mongkolsamrit, N. Kobmoo, P. Srikitikulchai, U. Pinruan, P. Khamsuntorn, S. Sommai, holotype BBH 47499, ex-type living culture BCC 90870.
Habitat:
Buried in the ground.
Host:
Larva (Coleoptera).
Description:
 Stromata two to several, simple, clavate to irregularly shaped, branched, up to 4.5 cm long, 1.5-2 mm wide. Rhizoids flexuous, arising from region between head, thorax, and abdomen of Coleoptera larvae, ca 2-3 cm buried in the ground. Upper part of the stromata fertile, pale yellow to olive yellow, 0.5-3 cm long, 2-4 mm wide.
Stromata two to several, simple, clavate to irregularly shaped, branched, up to 4.5 cm long, 1.5-2 mm wide. Rhizoids flexuous, arising from region between head, thorax, and abdomen of Coleoptera larvae, ca 2-3 cm buried in the ground. Upper part of the stromata fertile, pale yellow to olive yellow, 0.5-3 cm long, 2-4 mm wide.  Perithecia semi-immersed, ordinal in arrangement with slightly protuberant ostioles, ovoid, 500-650 × 270-330 μm.
Perithecia semi-immersed, ordinal in arrangement with slightly protuberant ostioles, ovoid, 500-650 × 270-330 μm.  Asci cylindrical, 8-spored, 280-320 × 5-6 μm, apical cap prominent, 5-6 × 5-6 μm.
Asci cylindrical, 8-spored, 280-320 × 5-6 μm, apical cap prominent, 5-6 × 5-6 μm.  Ascospores filiform, with septa but do not dissociate into part-spores, hyaline, 200-315 × 1.5-2 μm. The asexual morph was seen only on one sample in nature. The sporulating conidiophores are produced on the body and on rhizoids from the insect host which are buried in the ground, dark green. Conidia smooth walled, cylindrical with rounded apices, 8-12 × 3 μm.
Ascospores filiform, with septa but do not dissociate into part-spores, hyaline, 200-315 × 1.5-2 μm. The asexual morph was seen only on one sample in nature. The sporulating conidiophores are produced on the body and on rhizoids from the insect host which are buried in the ground, dark green. Conidia smooth walled, cylindrical with rounded apices, 8-12 × 3 μm.
Culture characteristics:
Colonies on PDA attaining a diam of 8 mm in 14 d, white mycelium, low density, fluffy, irregular edge, turning to dark green in the centre of colonies due to production of conidia. Sporulation starts at 14 d after inoculation. Conidiophores terminating in branches, with 2–3 phialides per branch, single phialides produced along the hyphae. Phialides cylindrical with semi-papillate apices, 7–10 × 2–3 μm. Conidia smooth-walled, dark green, cylindrical with rounded apices, 7–10 × 2–3 μm.
Colonies on PDA attaining a diam of 8 mm in 14 d, white mycelium, low density, fluffy, irregular edge, turning to dark green in the centre of colonies due to production of conidia. Sporulation starts at 14 d after inoculation. Conidiophores terminating in branches, with 2–3 phialides per branch, single phialides produced along the hyphae. Phialides cylindrical with semi-papillate apices, 7–10 × 2–3 μm. Conidia smooth-walled, dark green, cylindrical with rounded apices, 7–10 × 2–3 μm.
Reference:
Mongkolsamrit S, Khonsanit A, Thanakitpipattana D, et al. (2020). Revisiting Metarhizium and the description of new species from Thailand. Studies in Mycology 95: 171–251.
DOI: https://doi.org/10.1016/j.simyco.2020.04.001Species |
Strain |
Compound |
Pubchem CID |
Biological activity |
Reference |
|---|
|
Strain |
LSU | RPB1 | RPB2 | SSU | TEF1 |
|---|---|---|---|---|---|
| BCC 90870 | MN781874 | MN781776 | MN781822 | MN781965 | MN781731 |
| BCC 90874 | MN781875 | MN781777 | MN781823 | MN781966 | MN781732 |